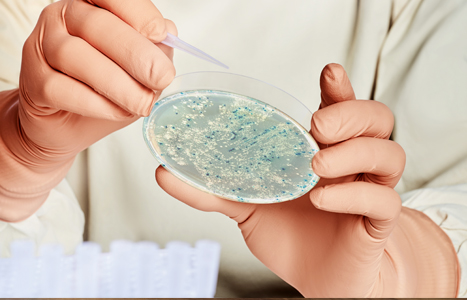

O LAMIC atua no mercado há 12 anos, consolidou sua imagem de empresa competente, ética e de elevado padrão profissional, com larga experiência em implementação de sistemas de garantia da qualidade de alimentos, em todos os elos da cadeia produtiva.
Nossa equipe é composta por químicos, veterinários, nutricionistas e técnico em controle de qualidade dos alimentos, com larga experiência em treinamento de pessoal em segurança alimentar. Sua sede em Aracaju, dispõe de Laboratório próprio, adequadamente equipado, e de uma equipe de profissionais qualificados e prontos a atendê-los no segmento de análises microbiológicas de alimentos e água, análise através de swab das mãos dos manipuladores e de utensílios em geral, consultoria em segurança alimentar e desenvolvimento de Manual de Boas Práticas e pop´s. O Laboratório utiliza equipamentos e instrumentos atualizados, mantidos e calibrados regularmente, onde os ensaios são realizados através de metodologias reconhecidas e validadas, buscando sempre a excelência dos serviços prestados.

aos clientes, oferecendo soluções
de maneira ágil e assertiva.
no respeito, responsabilidade,
profissionalismo, confidencialidade,
comprometimento com os resultados
e ética profissional.

a confiança do consumidor através da
consultoria em segurança alimentar em
estabelecimentos que manipulam ou fabricam
alimentos através das boas práticas e
análises microbiológicas.
e auditória em segurança alimentar e
análises microbiológicas.